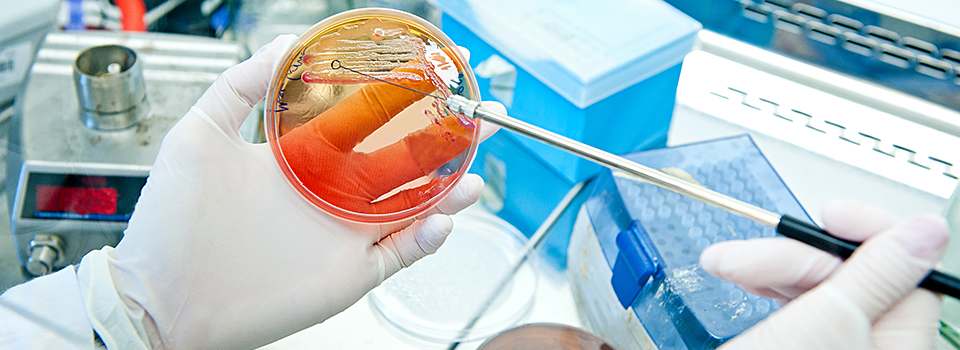

Kord-Valmark Labware Products
Kord-Valmark Labware Products by Bioplast Manufacturing, L.L.C. is a leading manufacturer of quality petri dishes. Our technical knowledge, experience and manufacturing capabilities – along with our superior mold design, precise process control and rigorous quality programs – allow us to manufacture the highest-quality products. Kord-Valmark’s disposable dishes provide unrivaled consistency, ease of use and exceptional value.